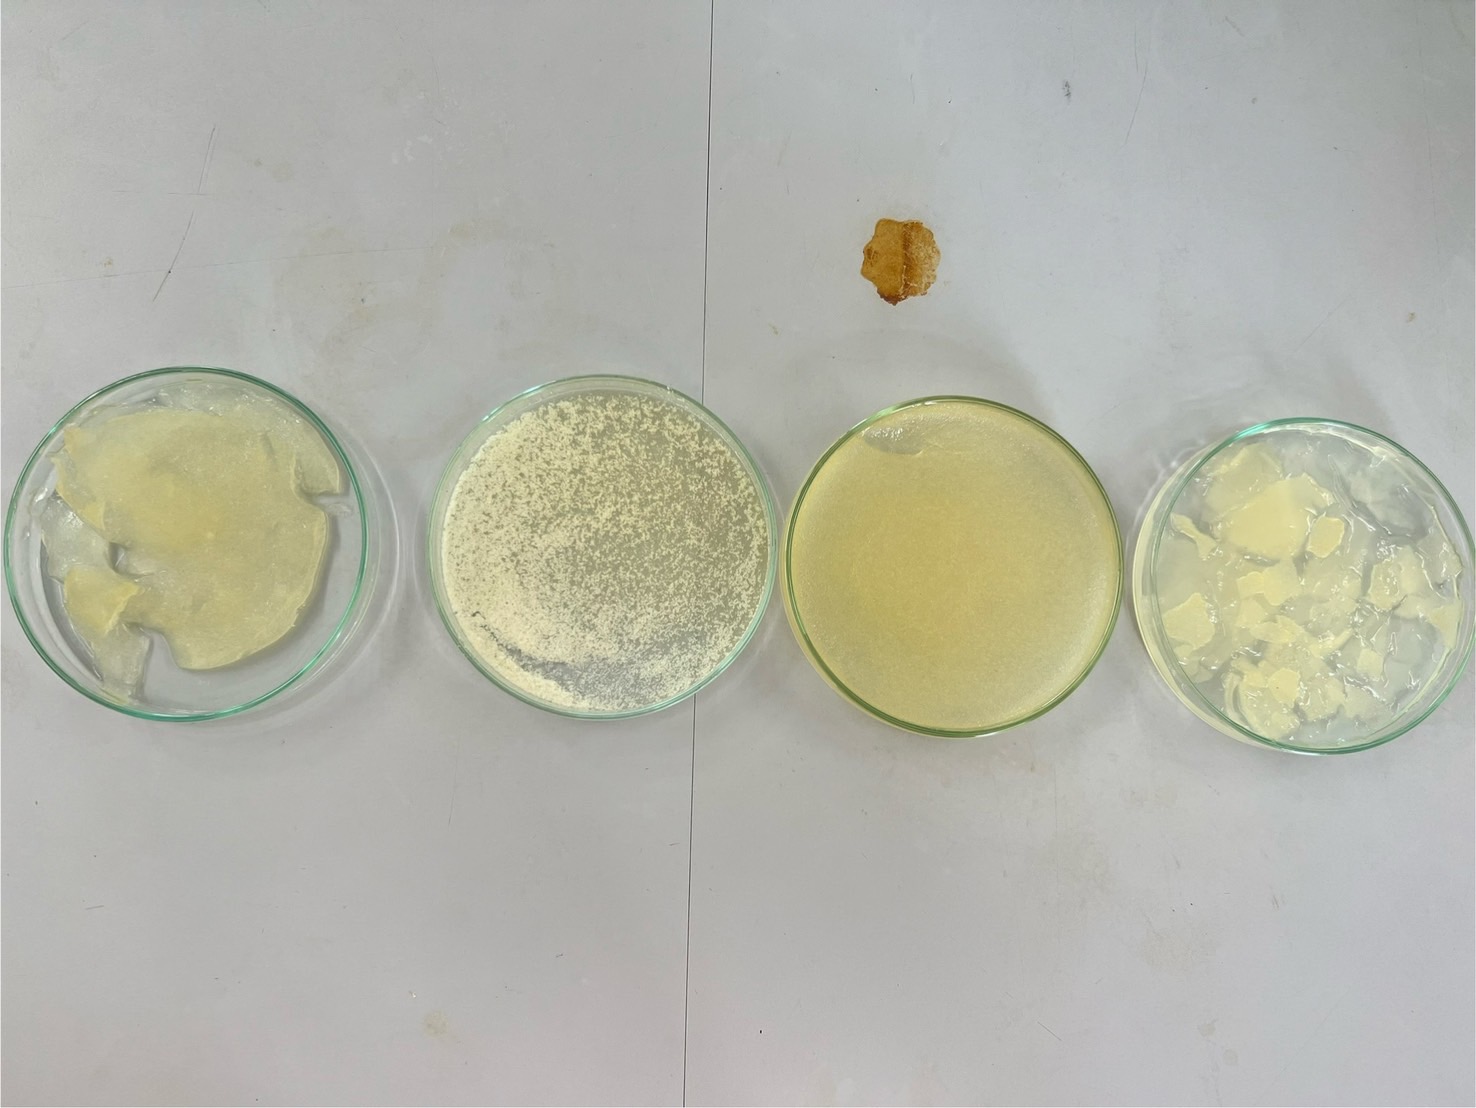

|
SISU-007:Fourier Transform Infrared Spectroscopy (FT-IR) |
|
โปรเจคนิสิต ป.ตรี หาหมู่ฟังก์ชันของตัวดูดซับ |
|
วุธณา สุทธิประภา |
| เริ่ม: |
16-09-2024 10:00 |
| ถึง: |
16-09-2024 11:00 |
|
|
|
นิสิตปริญญาตรี |
|
จอง |
|
1.ตัวดูดซับที่ทำจากเส้นใยเซลลูโลส
2.ตัวดูดซับที่ทำจากเส้นใยเซลลูโลส+PEI
- Chitosan (ผง)
- Chi-e-PEI (beads)
- Chi-e-PEI+Cr (beads) |
|
นายวุธณา สุทธิประภา |
|
อาจารย์ อรอนงค์ ชีระโรจน์ |
| รูป |
|
| วันเวลาในการลงทะเบียนจอง |
2024-09-11 17:02:18 |

